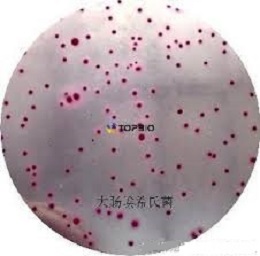
麦康凯琼脂培养基(MACC)

麦康凯琼脂培养基(MACC)
询价
250g/瓶
起订
北京 更新日期:2026-04-05
产品详情:
- 中文名称:
- 麦康凯琼脂培养基(MACC)
- 产品类别:
- 培养基
- 名称:
- 麦康凯琼脂培养基(MACC)
公司简介
北京三药科技开发公司是中国食品药品检定研究院(简称中检院)下属全资国有企业,在中检院领导下,自主管理和经营,是国内最早从事微生物脱水培养基研发、生产和销售的企业。
北京三药科技开发公司成立于上世纪九十年代,自成立伊始,秉承中检院严谨、务实的科学作风和工作传统,建立了严格的生产和质量管理体系。2016年,获得中国合格评定国家认可委员会(CNAS)颁发的国家实验室认可证书,同年,通过了ISO9001:2015质量体系认证。2017荣获高新技术企业称号。公司所有产品均由中国食品药品检定研究院监制。
依托中检院强大的科研技术实力,北京三药以科技创新作为企业发展的先导,在中检院专家指导下,先后研发成功“定量工作菌株”、“安洁清实验室玻璃器皿专用洗涤剂”、“无菌预制培养基”……等等一批填补国内空白或者技术质量水平国内遥遥领先的新技术和新产品,取得广大用户的认可和欢迎。
北京三药科技开发公司秉承“诚信、厚德、进取”的企业宗旨,竭诚为广大科研工作者和客户提供最专业的产品和最真诚的服务。
| 成立日期 | (34年) |
| 注册资本 | 15.000000万人民币 |
| 员工人数 | 10-50人 |
| 年营业额 | ¥ 500万-1000万 |
| 经营模式 | 服务 |
| 主营行业 | 生物化工 |
麦康凯琼脂培养基(MACC)相关厂家报价 更多
-

- 麦康凯琼脂培养基基础
- 上海冠导生物工程有限公司 VIP
- 2026-04-09
- 询价
-
![麦康凯[MAC]琼脂培养基基础](https://img.chemicalbook.com/SupplyImg/2020-06-02/Large/202006020856437812044.jpg)
- 麦康凯[MAC]琼脂培养基基础
- 上海宾穗生物科技有限公司 VIP
- 2026-04-09
- ¥422
-

- 山梨醇麦康凯琼脂培养基:Sorbitol MacConkey Agar (CT-SMAC Agar Base)
- 上海弘顺生物科技有限公司 VIP
- 2026-04-09
- 询价